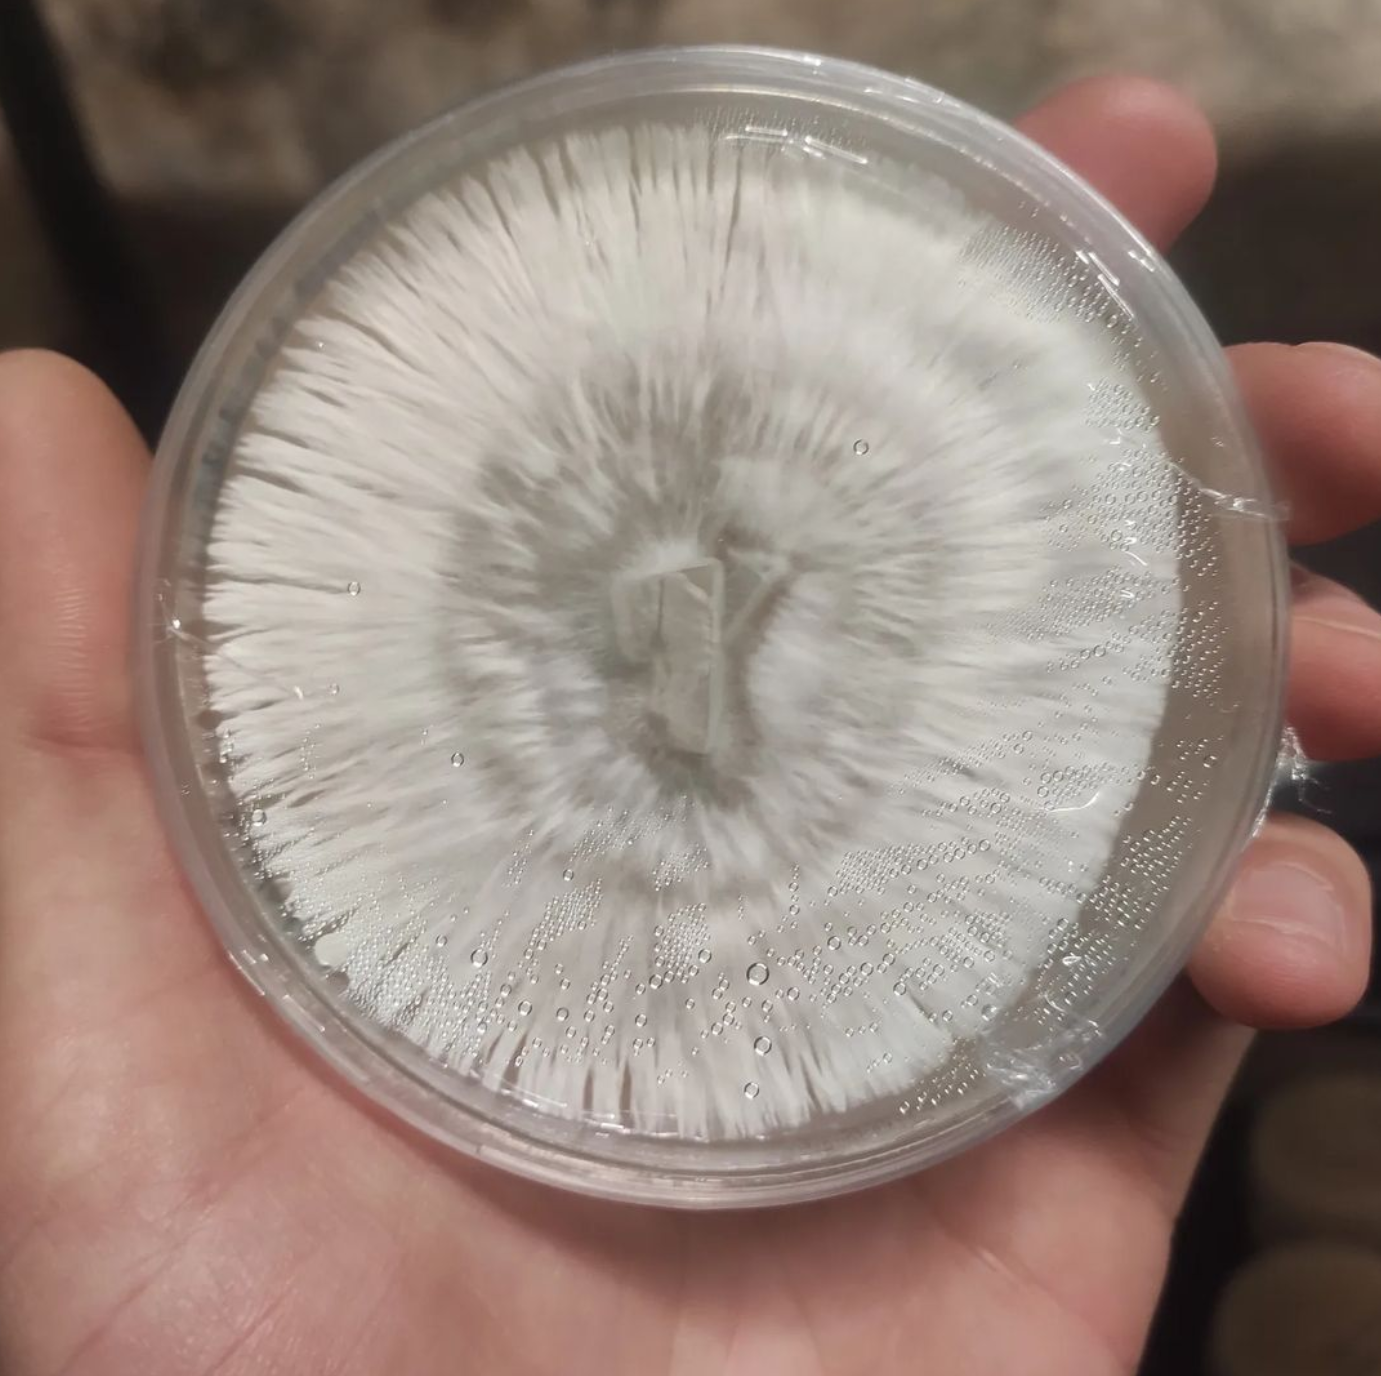

MissionMycelium
Cultures on agar
Cultures on agar
Regular price
CHF 25.00
Regular price
Sale price
CHF 25.00
Unit price
per
Tax included.
Couldn't load pickup availability
Introducing our Mushroom Agar Cultures, the key to unlocking a world of mycological wonders right in your own home!
Designed for the passionate mycologists and mushroom enthusiasts, our agar cultures provide a reliable and convenient way to propagate and study a wide variety of mushroom species.
Each culture is meticulously prepared with precision and care. Our agar cultures ensure optimal growth conditions, promoting robust mycelium development and consistent results.